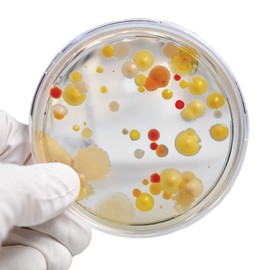
Steve Spangler's Growing Bacteria Science Experiment Kit

FILTER BY
Subscribe To Our Newsletter
Disclaimer: Statements made, or products sold through this website, have not been evaluated by the United States Food and Drug Administration. Products are not intended to diagnose, treat, cure or prevent any disease.
Set where you live, what language you speak, and the currency you use.
Learn more.